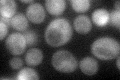
YML057W
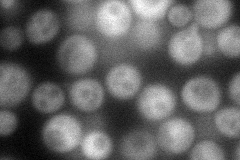
YML057W
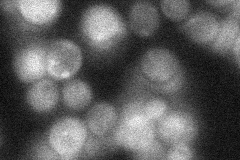
YML057W
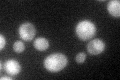
YML057W

View description
Calcineurin A; one isoform (the other is CNA1) of the catalytic subunit of calcineurin, a Ca++/calmodulin-regulated protein phosphatase which regulates Crz1p (a stress-response transcription factor), the other calcineurin subunit is CNB1
Localization:
Intensity:
Fold change:
Significance:
-
C’ GFP library in SD
cytosol42.8 -
N' NOP1pr-GFP in SD
cytosol91.5036 -
N' TEF2pr-mCherry in SD

cytosol140.589 -
N' NATIVEpr-GFP in SD
cytosol30.1704 -
N' TEF2pr-VC and Cyto-VN in SD

cytosol41.9968 -
C’ GFP library in SD+DTT

cytosol67.811.58Yes -
C’ GFP library in SD+H2O2

cytosol53.231.24No -
C’ GFP library in Starvation Media
cytosol65.61.53Yes -
C’ GFP library on the background of Pup2-DaMP

cytosol -
C’ GFP library on the background of CCT mutant

cytosol46.56051.08773No
